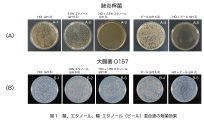
酒で胃を殺菌！？

初心者が奇数の完全数の存在証明に挑む話
初めまして。! Q. 完全数って何? A. 自身の約数の和が自身の2倍になる数です 例)6, 28, 496, 8128, 33550336 etc... 6の場合は1+2+3+6で12なので完全数です。 ...
酒で胃を殺菌!?
「酒で胃の中を殺菌」という冗談話は本当かも知れない。胃の中は胃酸(塩酸)の分泌により酸性である。口から入った微生物の多くは,胃酸によって殺菌される。ただ,空腹時は強い酸性(pH ...
研究支援エナゴ・無料オンラインセミナー「ジャーナル編集長が語る論文出版の舞台裏」
研究支援エナゴ・無料オンラインセミナー 「ジャーナル編集長が語る論文出版の舞台裏」開催!論文投稿の受理までのプロセスや学術出版の裏側について、3名のパネリストがライブで語るオンラインイベント。2023年12月6日(水)20時から ...
編集長が語る論文出版の舞台裏
研究支援エナゴ・無料オンラインセミナー「ジャーナル編集長が語る論文出版の舞台裏」開催! 論文投稿の受理までのプロセスや学術出版の裏側について3名の専門家が語る。2023年12月6日(水)20時から @Zoom ...
SNSによる症例調査:アニサキス食中毒に正露丸が効く
アニサキス幼虫は、サバやカツオなどの刺身に隠れている2〜3cmくらいの線虫で、この線虫は胃や腸の粘膜に頭部を突き刺して暴れ回り、アニサキスから分泌される物質によるアレルギー反応により七転八倒するほどの腹部の激痛が起きる。ほとんどの場合は、
研究支援エナゴが無料オンラインイベント「英文校正の舞台裏:トップ校正者によるライブ校正―生物医学・生化学編ー」を開催
研究・論文出版支援のソリューションを提供する研究支援エナゴ(enago)を運営するクリムゾンインタラクティブ(Crimson Interactive Pvt. Ltd. インド ムンバイ、代表:シャラド・ミッタル (Sharad ...
研究支援エナゴが無料オンラインイベント「ジャーナル編集者が教える『論文アクセプト』の実践ヒント」を開催
研究・論文出版支援のソリューションを提供する研究支援エナゴ(enago)を運営するクリムゾンインタラクティブ(Crimson Interactive Pvt. Ltd.インド ムンバイ、代表:シャラド・ミッタル (Sharad ...
論文の剽窃チェックとAI自動英文校正が同時に利用できるサービスの提供を開始【研究支援エナゴ】
このたび、研究および論文出版支援のソリューションを提供する研究支援エナゴ(enago)を運営するクリムゾンインタラクティブ(Crimson Interactive Pvt. Ltd.インド ムンバイ、代表:シャラド・ミッタル ...